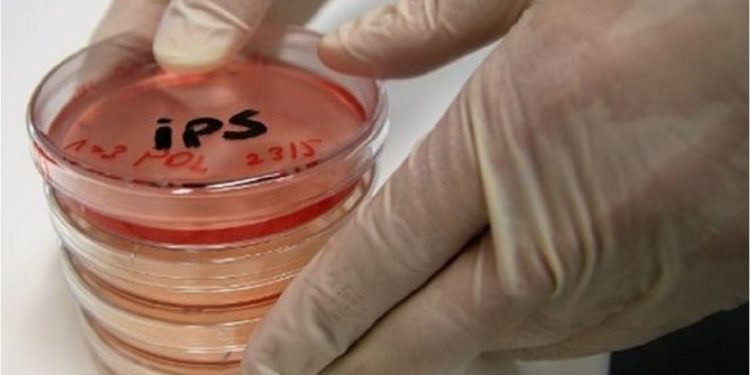
Japón probará células iPS para tratar lesiones de médula espinal

Este tratamiento experimental será el primero de este tipo realizado en el mundo con células de pluripotencia inducida.
Se espera que esta aplicación clínica pueda ampliar las posibilidades de los tratamientos regenerativos y suponga un avance hacia la medicina personalizada.
Este tipo de unidades morfológicas poseen la capacidad de convertirse en cualquier tipo celular especializado.
La prueba clínica será practicada por investigadores de la Universidad de Keio (Tokio) sobre cuatro pacientes con la médula dañada y pérdidas de movilidad de diferente grado tras sufrir accidentes, según confirmó a Efe un portavoz del Ministerio.
Este tratamiento experimental será el primero de este tipo realizado en el mundo con células iPS, y la quinta aplicación médica en Japón de esta técnica a una enfermedad o lesión concreta.
Las células de pluripotencia inducida ya se han utilizado anteriormente en diferentes proyectos de científicos nipones para hacer trasplantes de retina y para tratar el párkinson o una enfermedad ósea extremadamente rara.
El nuevo proyecto se probará este verano bajo la dirección del profesor de la Universidad de Keio Hideyuki Okano, y con la colaboración de la Universidad de Kioto, una institución de referencia en este campo y en la que se cultivarán las células iPS «reprogramadas» para integrarse en la médula de los pacientes.
Los investigadores comprobarán si los trasplantes de iPS son seguros y eficaces para tratar las lesiones de médula, que cada año afectan a unas 5.000 personas en Japón, según datos del Ministerio de Sanidad.

Dejá tu comentario